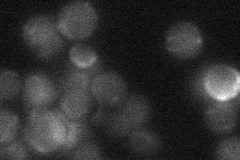
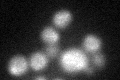

View description
2-methylisocitrate lyase of the mitochondrial matrix, functions in the methylcitrate cycle to catalyze the conversion of 2-methylisocitrate to succinate and pyruvate; ICL2 transcription is repressed by glucose and induced by ethanol
Localization:
Intensity:
Fold change:
Significance:
-
C’ GFP library in SD

mitochondria22.58 -
N' NOP1pr-GFP in SD

mitochondria116.772 -
N' TEF2pr-mCherry in SD

mitochondria128.573 -
N' NATIVEpr-GFP in SD
below threshold17.7627 -
N' TEF2pr-VC and Cyto-VN in SD

#N/A0 -
C’ GFP library in SD+DTT
mitochondria24.361.07No -
C’ GFP library in SD+H2O2

mitochondria24.661.09No -
C’ GFP library in Starvation Media

mitochondria17.940.79Yes -
C’ GFP library on the background of Pup2-DaMP

mitochondria -
C’ GFP library on the background of CCT mutant

mitochondria23.66181.04738No
